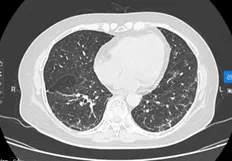

Ung thư phổi được chia thành hai loại chính là ung thư phổi tế bào nhỏ (small cell lung cancer) và ung thư phổi không tế bào nhỏ (non small cell lung cancer), trong đó nhóm ung thư phổi không tế bào nhỏ (NSCLC) chiếm tỷ lệ đa số, lên đến khoảng 85%.
Điều trị bệnh ung thư phổi cũng tuân theo quy tắc điều trị đa mô thức tương tự như các ung thư khác, là sự phối hợp giữa: phẫu thuật, xạ trị, điều trị nội khoa (hoá chất, đích, miễn dịch, sinh học, nội tiết…). Trong đó, điều trị toàn thân UTPKTBN chiếm vai trò quan trọng, đặc biệt đối với giai đoạn tiến triển tại chỗ hoặc di căn xa. Những thập kỷ gần đây bức tranh điều trị UTPKTBN đã chứng kiến sự chuyển đổi mô hình mang tính bước ngoặt, từ chủ yếu phụ thuộc vào liệu pháp hoá trị gây độc tế bào (cytotoxic chemotherapy) sang các liệu pháp ít gây độc tế bào khác như Ức chế đích phân tử (Molecularly Targeted Inhibition) hay liệu pháp miễn dịch (Immunotherapy). Các tiến bộ khoa học này dựa trên việc giải mã các cơ chế sinh ung thư (oncogenesis), đặc biệt là việc xác định các Đột biến dẫn đường (Driver Oncogene Mutations), như thụ thể yếu tố tăng trưởng biểu bì (EGFR), tái sắp xếp gen ALK, và ROS1…
Khái niệm Điều trị đích (Targeted Therapy) đề cập đến việc sử dụng các phân tử nhỏ hoặc kháng thể đơn dòng nhằm ức chế hoạt động của các protein hoặc con đường tín hiệu (signaling pathways) bất thường, vốn là yếu tố then chốt thúc đẩy sự tăng sinh và tồn tại của tế bào ung thư. Khác biệt căn bản với hóa trị, liệu pháp đích cung cấp một mức độ chọn lọc cao hơn đối với tế bào đích, dẫn đến hiệu quả điều trị được tối ưu hóa và giảm thiểu đáng kể độc tính toàn thân.
Sơ đồ Minh họa Cơ chế Tác động

Hình 1. Sơ đồ cơ chế tác động EGFR-TKI.
Nguồn: “EGFR Signaling and its inhibition by EGFR inhibitors in NSCLC”- Patel R. 2014.

Hình 2: Sơ đồ cơ chế tác động của ALK-TKI và đường truyền tín hiệu ALK trong tế bào ung thư.
Nguồn: Holla V et al., “ALK signalling: Pathway figure” (2017)
Sự thành công của các tác nhân này đã mở ra những hướng đi khả quan trong điều trị UTPKTBN, không chỉ dừng lại ở việc kiểm soát bệnh lý dài hạn ở giai đoạn di căn mà còn tối ưu hóa khả năng chữa khỏi bệnh ở giai đoạn sớm.
I. Giai đoạn sớm (IB–IIIA) có khả năng phẫu thuật
Liệu pháp bổ trợ (Adjuvant Therapy) sau phẫu thuật triệt căn UTPKTBN giai đoạn sớm là tối quan trọng nhằm loại bỏ các vi di căn và giảm nguy cơ tái phát. Hiện nay, điều trị đích bổ trợ đã được chỉ định cho nhóm bệnh nhân UTPKTBN có đột biến gen sau phẫu thuật triệt căn, chủ yếu với 2 nhóm đột biến EGFR và ALK.
1. Đột biến EGFR: Bằng chứng nền tảng đến từ Nghiên cứu ADAURA, một thử nghiệm lâm sàng pha 3 trên bệnh nhân NSCLC giai đoạn IB–IIIA sau phẫu thuật triệt căn có đột biến EGFR thường gặp. Nghiên cứu đã chứng minh rằng việc sử dụng Osimertinib (EGFR-TKI thế hệ 3) trong ba năm sau phẫu thuật đã mang lại sự cải thiện có ý nghĩa thống kê về tỷ lệ sống thêm không bệnh (DFS), với Hazard Ratio (HR) là 0.27 (tương đương giảm 73% nguy cơ tái phát, di căn hoặc tử vong) ở nhóm giai đoạn IB–IIIA. Kết quả từ nghiên cứu này đã giúp Osimertinib được phê duyệt là một trong các liệu pháp điều trị bổ trợ tiêu chuẩn UTPKTBN [1]
2. Tái sắp xếp ALK: Một bước tiến quan trọng khác là kết quả từ Nghiên cứu ALINA, một thử nghiệm lâm sàng pha 3 so sánh Alectinib (thuốc kháng ALK thế hệ 2) với hóa trị bổ trợ tiêu chuẩn là các phác đồ nền tảng platinum ở bệnh nhân NSCLC giai đoạn IB–IIIA có tái sắp xếp ALK. Kết quả ban đầu của ALINA cho thấy Alectinib đã giảm khoảng 76% nguy cơ tái phát bệnh hoặc tử vong (HR=0.24), chứng minh hiệu quả vượt trội của thuốc kháng ALK thế hệ 2 so với hóa trị trong liệu pháp bổ trợ. Sự thành công này đang mở rộng phạm vi điều trị đích bổ trợ, không chỉ giới hạn ở EGFR mà còn bao gồm các đột biến khác [2]
3. Điều trị bổ trợ trước (Neoadjuvant): Các nghiên cứu về điều trị trước mổ (Neoadjuvant) hoặc điều trị trước-sau mổ (Perioperative) trong UTPKTBN giai đoạn II-III đều nhằm mục tiêu không chỉ giúp giảm giai đoạn (down-staging), tạo điều kiện thuận lợi hơn cho phẫu thuật, mà còn nhắm đến đạt đáp ứng hoàn toàn mô bệnh học (pCR), từ đó kéo dài thời gian sống còn của người bệnh. Các thử nghiệm đang tiến hành (NeoADAURA, NAUTIKA1) đang được tiến hành nhằm đánh giá hiệu quả của EGFR-TKI (Osimertinib) và các TKI khác trong liệu pháp tân bổ trợ, bước đầu cho thấy kết quả khả quan của nhóm điều trị TKI so với nhóm chứng về tỷ lệ pCR, MPR và cải thiện thời gian sống còn. [3], [4].
II. Giai đoạn tiến triển tại chỗ (giai đoạn III không mổ được): Vai trò kết hợp đa mô thức và điều trị củng cố
Liệu pháp củng cố (Consolidation): Đối với bệnh nhân giai đoạn III không thể phẫu thuật được, sau khi hoàn thành hóa xạ trị đồng thời (Concurrent Chemoradiation Therapy - cCRT) là điều trị tiêu chuẩn, các liệu pháp củng cố theo sau điều trị chuẩn đã chứng minh vai trò nhất định trong giảm nguy cơ bệnh tiến triển, giảm tỷ lệ tái phát và kéo dài thời gian sống còn toàn bộ (OS). Trong nhóm bệnh nhân này, Nghiên cứu PACIFIC đã chứng minh Durvalumab (một liệu pháp miễn dịch) là điều trị chuẩn mới trong chỉ định điều trị củng cố. Tuy nhiên, đối với nhóm bệnh nhân có đột biến gen (như EGFR và ALK), hiệu quả của liệu pháp miễn dịch còn hạn chế.
Kết quả nghiên cứu LAURA cho thấy việc dùng Osimertinib sau khi hoàn tất hoá xạ trị đồng thời giúp giảm 84% nguy cơ tiến triển hoặc tử vong so với giả dược (PFS trung vị 39,1 so với 5,6 tháng). Đặc biệt, thuốc còn kiểm soát tốt di căn não, nhờ khả năng xuyên hàng rào máu não vượt trội. Với bằng chứng này, Osimertinib trở thành điều trị tiêu chuẩn mới trong điều trị củng cố bệnh nhân ung thư phổi giai đoạn III không mổ được có đột biến EGFR, mang lại cơ hội kéo dài sống còn và tiến gần hơn đến mục tiêu “chữa khỏi” bệnh [5].
III. Giai đoạn Di căn xa (giai đoạn IV)
Trong bối cảnh điều trị UTPKTBN giai đoạn di căn, việc tìm ra các đột biến dẫn đường (driven mutations) và các thuốc nhắm đích tương ứng đã làm thay đổi cách tiếp cận điều trị bước một.
Theo các dữ liệu đã được thống kê, tỷ lệ xuất hiện các đột biến EGFR, ALK, ROS1, KRAS… có thể khác nhau tuỳ từng khu vực, rõ nét nhất là giữa nhóm dân Châu Á và dân số các khu vực còn lại.

Hình 3: Phổ đột biến UTKTBN- Annu. Rev. Med. 2020. 71:117–36
1. Các Thế hệ EGFR-TKI đầu tiên (TKI Thế hệ 1 & 2): Lịch sử điều trị đích bệnh nhân UTPKTBN giai đoạn tiến xa, di căn có đột biến gen EGFR bắt đầu với các TKI thế hệ 1 (Gefitinib, Erlotinib) và thế hệ 2 (Afatinib, Dacomitinib). Các thử nghiệm lâm sàng kinh điển (như IPASS, LUX-Lung 3) đã chứng minh hiệu quả làm cải thiện đáng kể thời gian sống thêm bệnh không tiến triển (PFS) của nhóm EGFR-TKI so với liệu pháp hóa trị là điều trị tiêu chuẩn trước đó. Tuy nhiên, hiệu quả lâm sàng của các thế hệ đầu tiên này thường chỉ kéo dài khoảng 9–13 tháng, và hầu hết bệnh nhân xuất hiện cơ chế kháng thuốc mắc phải, phổ biến nhất là đột biến T790M.
2. Đột phá của TKI thế hệ ba: Sự ra đời của Osimertinib là một bước tiến mang tính đột phá. Đây là một TKI thế hệ 3, được thiết kế để vượt qua cơ chế kháng thuốc T790M, đồng thời có hiệu lực mạnh mẽ đối với các đột biến EGFR thường gặp.
- Nghiên cứu FLAURA: Nghiên cứu này đã chứng minh hiệu quả cải thiện PFS vượt trội (PFS trung vị 18,9 tháng) của Osimertinib so với TKI thế hệ 1, cũng như cải thiện thời gian sống còn toàn bộ OS, giúp TKI này trở thành lựa chọn ưu tiên trong điều trị bước một UTPKTBN giai đoạn tiến xa di căn có đột biến EGFR thường gặp.
- Kiểm soát di căn CNS: Khả năng thâm nhập hàng rào máu não hiệu quả của Osimertinib đã giúp cải thiện đáng kể việc kiểm soát di căn hệ thần kinh trung ương, một yếu tố then chốt ảnh hưởng đến tiên lượng và chất lượng cuộc sống (QoL) của bệnh nhân.
Ngoài EGFR là đột biến phổ biến, các đột biến khác hiếm gặp hơn như ALK, ROS1, KRAS, BRAF, NRAS, MET… cũng đã có các thuốc điều trị nhắm đích tương ứng cho kết quả khả quan so với điều trị hoá trị kinh điển, chủ yếu ở trên nhóm bệnh nhân UTPKTBN giai đoạn tiến xa di căn qua bảng minh hoạ dưới đây.

Chúng tôi xin minh hoạ hiệu quả điều trị liệu pháp nhắm đích EGFR và ALK qua 2 ca lâm sàng thực tế được điều trị tại bệnh viện
Ca lâm sàng 01:
BN nữ L.T.K.L (SN 1987), nhập viện tại thời điểm tháng 07/2019 vì lý do co giật, yếu 1/2 người trái. Bệnh nhân xuất hiện các cơn đau đầu âm ỉ với tần suất tăng dần từ thời điểm trước khi nhập viện 4-5 tháng, đã đi khám tại một số bệnh viện và điều trị không giảm, bệnh nhân sau đó xuất hiện cơn co giật, được đưa vào cấp cứu tại BV Bạch Mai, hình ảnh chụp MRI sọ não cấp cho thấy các khối di căn lan toả 2 bán cầu, chủ yếu bán cầu não phải, hình ảnh cắt lớp vi tính ngực gợi ý tổn thương nguyên phát từ phổi. Bệnh nhân được giải thích tình trạng nặng, sau đó được chuyển sang BV Ung Bướu Hà Nội điều trị giảm nhẹ. Rất may mắn tại bệnh viện Ung Bướu Hà Nội, bệnh nhân được rà soát các tổn thương toàn thân và cuối cùng được sinh thiết hạch cổ làm chẩn đoán. Giải phẫu bệnh hạch cổ có kết quả di căn ung thư biểu mô tuyến nguồn gốc phổi, xét nghiệm giải trình tự gen cho kết quả dương tính với đột biến tái sắp xếp ALK. Bệnh nhân được tiếp cận điều trị thuốc kháng ALK thế hệ 2- Ceritinib, chỉ sau 1 tháng bệnh nhân hồi phục hoàn toàn các triệu chứng về thần kinh trung ương, đi lại vận động sinh hoạt như bình thường. Kết quả chụp lại MRI sọ não và CLVT ngực sau 02 tháng điều trị cho thấy hình ảnh đáp ứng sớm và ngoạn mục với liệu pháp nhắm đích.

Hình 4: tổn thương di căn não trên MRI trước điều trị

Hình 5: tổn thương MRI não sau điều trị
Ca lâm sàng 02
BN nữ P.T.H, sinh năm 1967, nhập viện vào thời điểm tháng 04/2024 vì lý do ho khan kéo dài, khó thở khi gắng sức, kèm theo đau nhiều cột sống ngực, thắt lưng. Kết quả kiểm tra ban đầu cho thấy hình ảnh tổn thương u phổi nhiều khối lan toả 2 phế trường, kèm theo di căn xương đa ổ. Kết quả sinh thiết vào vị trí u thuỳ dưới phổi phải là ung thư biểu mô tuyến phổi, xét nghiệm giải trình tự gen thế hệ mới NGS phát hiện đột biến xoá đoạn trên exon 19 gen EGFR (del19/EGFR). Bệnh nhân được lựa chọn liệu pháp nhắm đích ưu tiên là thuốc nhắm đích EGFR-TKI thế hệ 3, sau 6 tuần điều trị, tổn thương phổi 2 bên đáp ứng gần hoàn toàn trên CLVT ngực, bệnh nhân giảm đau rất nhiều tại tổn thương di căn xương cột sống, có thể sinh hoạt đi lại được, hoàn toàn không còn triệu chứng cơ quan hô hấp như ho hay tức ngực, khó thở.

Hình 6: tổn thương phổi trước điều trị
Hình 7: tổn thương phổi sau 06 tuần điều trị và hình ảnh hiện tại
Còn rất nhiều ca bệnh UTPKTBN sau điều trị với liệu pháp nhắm đích đã đạt được “kỳ tích” ngoạn mục, 02 ca lâm sàng trên đây là số ít ca được chia sẻ kèm dẫn chứng minh hoạ về hình ảnh để quý bạn đọc có thể hình dung một cách sinh động hơn về hiệu quả diệu kỳ của liệu pháp ít độc tế bào này.
Kết Luận: Điều trị nhắm trúng đích (Targeted therapy), với cơ chế tác động dựa trên nguyên lý “ổ khoá-chìa khoá”, đã và đang là một trong các điều trị chuẩn mực trên bệnh nhân UTPKTBN ở các giai đoạn khác nhau, từ việc tăng khả năng chữa khỏi ở giai đoạn sớm đến việc cải thiện chất lượng và kéo dài sự sống ở giai đoạn di căn. Hiệu quả thực tế được chứng minh từ các nghiên cứu lâm sàng (ADAURA, ALINA, FLAURA…) khẳng định thêm vai trò của các liệu pháp nhắm đích trong thực hành điều trị, nhằm mang lại lợi ích tối đa, kéo dài sống còn và nâng cao chất lượng cuộc sống cho người bệnh.
Viết bài: ThS. BS Trần Thanh Hà - Khoa Nội tổng hợp Theo yêu cầu
Duyệt bài: TS. BS Lê Thu Hà - Trưởng khoa Nội Phổi - Vú



















